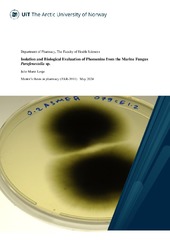

Isolation and Biological Evaluation of Phomenins from the Marine Fungus Parafenestella sp.
Permanent lenke
https://hdl.handle.net/10037/33789Dato
2024-05-15Type
MastergradsoppgaveMaster thesis
Forfatter
Lesjø, Julie MarieSammendrag
Background: Marine fungi are prolific producers of secondary metabolites. Phomenin A (2) and B (3) are secondary metabolites produced by Parafenestella sp. Previous studies have described them as bioactive, but due to the limited availability of pure compounds, their bioactivity has yet to be extensively characterised. These compounds were identified and isolated at Marbio, but the quantities obtained were insufficient for proper bioactivity profiling. Therefore, the aim of this thesis was to produce larger amounts of the compounds and isolate them to perform proper bioactivity profiling. Additionally, 22 marine fungi extracts were screened for bioactivity to identify new bioactive compounds.
Method: Parafenestella sp. and a selection of other marine fungi were inoculated and cultivated for one month in liquid media. The resulting biomass was filtered and extracted using liquid-liquid extraction. The 22 marine fungi extracts were screened for cytotoxic, antibacterial, and antidiabetic properties. The Parafenestella sp. extract was fractionated using flash chromatography and then analysed using high-resolution mass spectrometry (HR-MS) to verify the presence of the target compounds. The phomenins were subsequently isolated using preparative HPLC in the fractions from Parafenestella sp. Pure isolated compounds were tested for cytotoxic, antidiabetic and antibacterial growth inhibition properties.
Results: Phomenin A (2) and B (3) were successfully isolated and characterised. The isolation yielded 0.6 mg of phomenin A (2) and 0.4 mg of phomenin B (3). Phomenin A (2) was considered antibacterial at 200 µM when tested against S. agalactiae. A cytotoxic assay was also run using the cell lines MCF7 (malignant cells) and MRC-5 (non-malignant cells), but no activity was observed. In addition, the isolated compounds were tested for antidiabetic activity in DPP-IV and PTP1B assay but were not categorised as active. A selection of marine fungi from the 22 isolates showed cytotoxic and antibacterial activity.
Conclusion: The present study isolated and characterized phomenin A (2) and B (3) from Parafenestella sp., demonstrating their bioactivity against bacterial strains. The study found them, though, to be too unstable and not potent enough for commercial drug development. Of the 22 marine fungi, four showed promising cytotoxic and antibacterial properties. Further research is needed to explore and identify the therapeutic potential of the secondary metabolites in these fungal extracts.
Forlag
UiT Norges arktiske universitetUiT The Arctic University of Norway
Metadata
Vis full innførselSamlinger
Copyright 2024 The Author(s)
Følgende lisensfil er knyttet til denne innførselen:


 English
English norsk
norsk